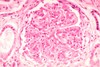

Disease of Kidneys I - Nephrotic & Others Flashcards
(57 cards)
What’s the main difference between nephritic and nephrotic syndromes?
nephritic = cellular proliferations
nephrotic = GBM damages (thickened with immune-complex infiltrates
What’s another name for minimal change disease?
liponephrosis or Mill disease
What population is at risk for minimal change disease?
pediatrics! (#1 cause of nephrotic disease in these patients)
minimal change for the mini people
What can effectively stop proteinuria in minimal change disease? (what’s treatment?)
steroids extremely effective - stops within 24hours
can use this as a test and avoid invasive biopsy (tapering off the steroids will not have recurrent proteinuria)
What is minimal change disease associated with?
atopic disorders (eczema, rhinitis) and respiratory infections and immunization
Is minimal change disease immune-complex mediated?
NO!
What is seen on EM of minimal change disease?
effacement of foot processes (looks like the epithelial cell cytoplasm is flattened out)

BM continuous
What is seen in H&E of minimal change disease?
looks normal!

What is seen in fluorescence in minimal change disease?
NORMAL bc no immune complexes
Why is it called minimal change disease?
bc minimal changes! (duh) - only change at ultrastructural level - no immune complexes; no hypercellularity
What’s prognosis for minimal change disease?
good
What are some unique characteristics of focal segmental glomerusclerosis?
only SOME glomeruli affected - of this, only PARTS/SEGMENTS (patchy)
involves sclerotic/hyalinized lesion (NOT proliferation/cellularity)
Who is normally affected with focal segmental glomerusclerosis?
older children, young adults
What disease was focal segmental glomerusclerosis mistakenly subtyped as?
minimal change disease
shared characteristic: foot process fusion
differential: it posses focal, sclerotic lesions; recurs when taken off steroids (steroid-dependent); non-selective proteinuria (minimal change is selective - no immunoglobinemia)
What are some other characteristics of focal segmental glomerusclerosis?
idiopathic or associated with HIV or other forms of focal glomerulonephritis
may have some nephritic features
What’s seen in H&E of focal segmental glomerulosclerosis?
looks okay but have patchy foamy looking sclerosis - sclerotic/hyalinized lesions (not cellular)

What is shown here?

FSGS
have adhesions called synechiae- focal lesions on top (in purple) but the rest looks okay
What is seen in fluorescences of focal segmental glomerulosclerosis?
NOT immune mediated
but you do see entrapped proteins in sclerotic lesions - LOCALIZED

What is seen in EM of FSGS?
similar to minimal change in non-sclerotic segments!
effaced foot process of epithelial cells
What’s the treatmet for FSGS?
steroids, supportive
What’s the prognosis for FSGS?
poor - recurrence in transplants
tend to progress to global (lesions being fusing together) and chronic
What are the characteristics od mebranous nephrotic disease?
most common nephrotic syndrome in adults
idiopathic or secondary (drugs, malignancy, SLE, chronic infections [TB, HBV, HCV, parasites], metabolic disorders [thyroiditis], tumors)
secondary causes chronic antigenmia (Abs form immune complexes that deposits in microvasculature)
subepithelial immune complex deposits
What is seen in H&E of membranous nephrotic disease?
no hypercelluarity/prolferation (not nephritic)
looks like normal

What’s seen in FM of membranous nephrotic disease?
“lighting up like Christmas trees”
diffuse - every glomerulus have granular pattern